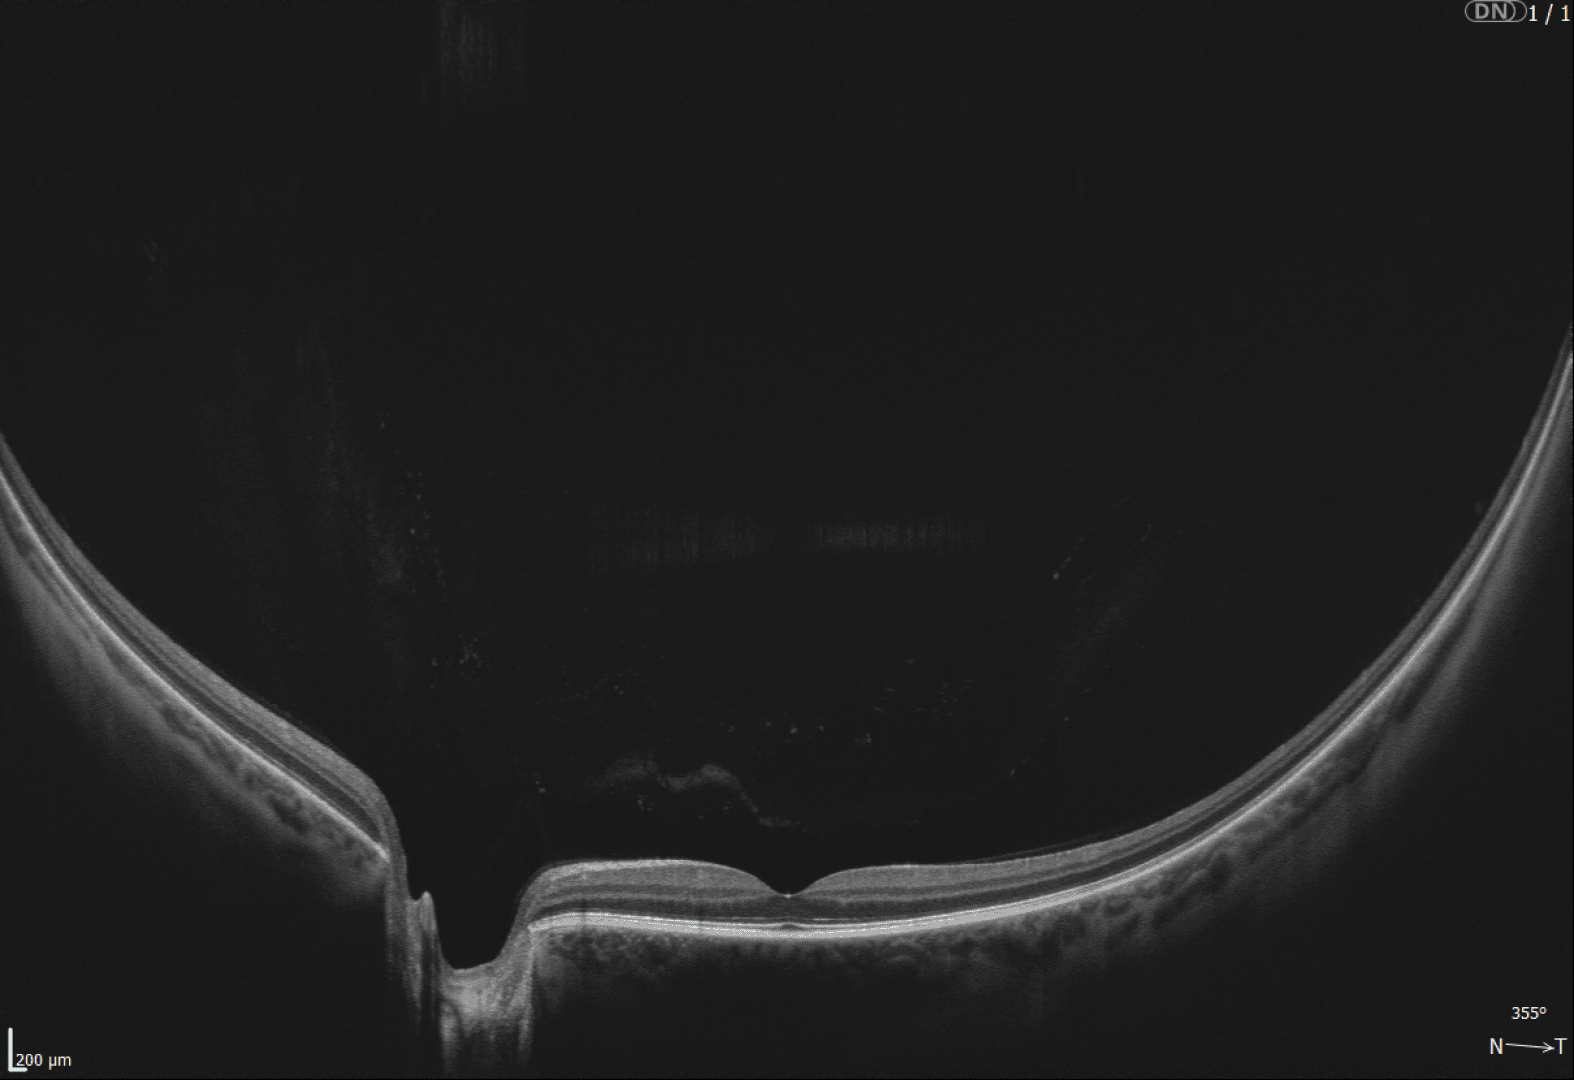
Schwarz-Weiß-Aufnahme eines Auges mit optischer Kohärenztomographie (OCT). Sie zeigt die Querschnittsschichten der Netzhaut und eine konkave Vertiefung, die den Sehnervenkopf oder die Makula darstellt. Der Maßstab ist unten links sichtbar.

REVO OCT's - KI-basiertes OCT-Screening so einfach wie nie
Die Optopol REVO OCT-Serie überzeugt durch einen beeindruckend breiten Funktionsumfang und ein hervorragendes Preis-Leistungs-Verhältnis. Von Netzhautscreening bis Myopie-Management - alles ist möglich. Testen Sie Ihr Wunschgerät unverbindlich in einer Demostellung in Ihrem Geschäft.
Entdecken Sie die REVO OCT-Familie von Optopol, die für jede Anwendung das passende Modell bietet. Die ideale Wahl für Preisbewusste ist das REVO ECO. Das REVO FC bietet eine integrierte Funduskamera. Oder das ultra-schnelle SD-OCT für höchste Ansprüche: das REVO NX 130 und das REVO FC 130 mit integrierter Funduskamera.
Alle Modelle überzeugen durch ihre Vollausstattung: Netzhaut-Screening, Glaukom-Analyse, Vorderabschnitt-Scans, Gonioskopie und Pachymetrie - alles vollautomatisch und gestützt durch eine normative Datenbank zur unabhängigen Befundbewertung. Optional erweitern Funktionen wie Biometrie, Hornhauttopographie und OCT-Angiographie die Einsatzmöglichkeiten.
Seit über 20 Jahren entwickelt Optopol Spitzentechnologie im Bereich der optischen Kohärenztomographie und hat mit der REVO OCT-Familie etwas geschaffen, das perfekt auf die Anforderungen von Anwendern in der Optometrie und Ophthalmologie zugeschnitten ist.
Lassen Sie uns gemeinsam herausfinden, welches REVO OCT am besten zu Ihren Bedürfnissen passt. Besuchen Sie uns auf der Messe am Stand C4.337 für ein persönliches Beratungsgespräch.